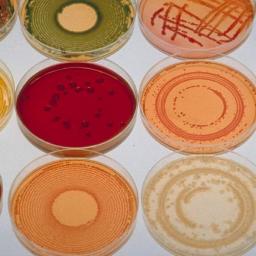
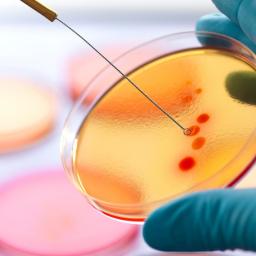

|
by Helena Smith in Athens on (#1F4N9)
Greek archaeologist ‘almost certain’ he has discovered the long-sought tomb of world’s greatest philosopherGreek archaeologists believe they have discovered the lost tomb of Aristotle, the greatest philosopher in history.Kostas Sismanidis said he was almost sure that a 2,400 year-old domed vault he unearthed in ancient Stagira was the burial place of the man credited with formalising logic. Continue reading...
|
| Link | http://feeds.theguardian.com/ |
| Feed | http://feeds.theguardian.com/theguardian/science/rss |
| Updated | 2026-06-28 16:31 |
 |
by Meghan Nesmith on (#1F4GR)
A simple spit test gives new meaning to ‘having chemistry’, as husband and wife analyze genetic material to find out whether couples are scientifically compatible“I wanna know what love is,†the song goes, and I think: yeah, me too. In 2015, 15% of Americans used an online dating service; if you are a butcher or baker or candlestick maker, there’s an app for you. Our modern dating industry is built on the idea that you are too much of a dummy to find love yourself, and it is now worth $2.4bn.The latest startup in this space is Instant Chemistry, a company built on the premise that your DNA could help you figure out who to love. Last month, I met co-founders Sara Seabrooke and her husband Ron Gonzalez at a nondescript laboratory in Toronto, surrounded by vials of spit.
|
 |
by Michael Jennings on (#1F4B6)
My father, Alan Jennings, who has died aged 93, was a pioneer in the field of radiotherapy for cancer treatment and radiation science.He was born to Leila (nee Shepherd) and Sylvanus Jennings in Geneva, where his father, a Quaker, was the European correspondent of the News Chronicle. Alan went to school in Geneva until his teens when he went as a boarder to the Friends’ school in Saffron Walden, Essex. Continue reading...
|
 |
by Associated Press on (#1F3VN)
Problems emerged while releasing air into experimental room at the International Space Station on Thursday, putting everything on holdNasa hit a snag while releasing air into an experimental inflatable room at the International Space Station on Thursday and put everything on hold for at least a day.Mission Control ordered astronaut Jeffrey Williams to call it quits after the operation had dragged on for more than two hours, with the compartment expanding just a few inches. The inflation process could resume as early as Friday, depending on what engineers learn. Continue reading...
|
 |
by Ian Sample Science editor on (#1F3G1)
Vaping medicinal cannabis would be healthier than smoking the drug with tobacco, researchers claim, and allow regular microdoses not possible with pillsElectronic cigarettes can be a safe and effective way to deliver cannabis for medicinal purposes, according to researchers in Switzerland.
|
 |
by Polly Morland on (#1F35T)
Changing who we are is hard to imagine, and even harder to actually do. But the good news is, it’s not impossibleThanks to the findings of the US psychologist Angela Duckworth, what gives you grit – and whether you can change to develop it – is very much on the agenda.We once intoned “Every day in every way, I’m getting better and betterâ€, or we machinated about winning friends and influencing people. But we barely paused for breath before turning to the cultivation of (seven) habits of highly effective people and, not long after, the winning ways of Outliers. And on it rolls – our hunger for remedies for mediocrity is as insatiable as ever. Continue reading...
|
 |
by Henry Nicholls on (#1F2VV)
A collection of zoological wonders from May 2016, featuring brave new rhinos, brand new pandas, earthworm engineers and more
|
 |
by Amanda Holpuch in New York on (#1F2TC)
First-of-its-kind analysis was inspired by older Americans at hearing clinics who complained about no longer being able to understand their favorite TV showsAcademics are studying whether British accents become unintelligible to Americans as they age.The first-of-its-kind analysis was inspired by older Americans complaining at hearing clinics about no longer being able to understand their favorite television shows, such as Keeping Up Appearances and PBS’s Masterpiece Theatre, which presents British series. Continue reading...
|
 |
by Press Association on (#1F14N)
Countries with universal health coverage have fewer casualties, according to Lancet study of cancer deathsHundreds of thousands of cancer deaths around the world may have occurred as a result of the recession of 2008, experts have said.
|
 |
by Paul Simons on (#1F0S1)
A late spring has brought meadow plants alive in May, but Britain’s natural grassland is continuing to disappearA late spring led to a big burst of wild flowers this month, but of all the native wild flowers how many green-winged orchid, oxlip, dyer’s greenweed and meadow clary have been seen?These are all meadow plants and they are becoming rare. The green-winged orchid is, despite its name, mostly pink or purple but with delicate green veins. Dyer’s greenweed is a shrubby plant, a great food plant for moths and like its names suggests was once used as a very good dye, especially for wool. Meadow clary has striking deep blue flowers, and the name “clary†came from “clear-eye†because the plant seeds were used as a paste to soothe and cleanse sore eyes. Continue reading...
|
 |
by Ian Sample Science editor on (#1F00E)
Constructions discovered deep in a French cave rank among the earliest human building projects ever discovered, but their purpose remains unclearMysterious structures found deep inside a French cave are the work of Neanderthal builders who lived in the region more than 100,000 years before modern humans set foot in Europe.The extraordinary constructions are made from nearly 400 stalagmites that have been yanked from the ground and stacked on top of one another to produce rudimentary walls on the damp cave floor.
|
 |
by Henry Nicholls on (#1F00G)
Faced with a rapidly fattening rival, meerkats respond by eating more in an urgent effort not to slip down the social hierarchy, a new study shows“Unfairness bothers children greatly.†This quotation comes from Karen Joy Fowler’s 2014 novel We Are All Completely Beside Ourselves and it comes to mind on an almost daily basis as I struggle to manage the tensions between my two pre-teen boys.It is also a sentiment that appears to apply to meerkats, according to a nifty little study out today. Continue reading...
|
 |
by Steven Poole on (#1EZ7Y)
We experience some kind of inner speech for at least a quarter of our waking lives. This helps some, while others set out to reduce the chatter. And how does it relate to God?When you talk to yourself, who exactly is doing the talking, and who the listening? Walt Whitman wrote: “Do I contradict myself? / Very well then I contradict myself. / (I am large, I contain multitudes.)†But who are these multitudes? And who let them all in? Thus does language tempt us to posit a concert hall of homunculi within the head.Charles Fernyhough’s fascinating and elegantly humane book is aware of the problem, but doesn’t attempt to solve it (doing so would probably require a true theory of consciousness). Instead he starts with the existence of what is technically termed “inner speechâ€, and sketches a theory of how it occurs. He inquires into its phenomenology (the feel of the subjective experience of talking to oneself), and he offers an intriguing developmental account of how we come to do it at all, and why it is so useful. Continue reading...
|
 |
by Susannah Lydon on (#1EZ68)
We tend to focus on the extinction of the dinosaurs, but the plant fossil record holds different parts of the story of life - and death - at the end of the CretaceousThe extinction event at the end of the Cretaceous Period, 66 million years ago, is the most well-known of the “Big Five†mass extinctions in the fossil record, even if it wasn’t the biggest. That accolade goes to the Great Dying at the end of the Permian Period, about 250 million years ago, when up to 96% of species became extinct. But since the dinosaurs weren’t around for that mass extinction, it hasn’t entered the popular consciousness in quite the same way.Like most things to do with mass extinctions, even the naming of the Cretaceous event is not without controversy. Many researchers still refer to it as the K-T extinction, where K refers, confusingly, to the Cretaceous (Kreide in German) and T stands for Tertiary (the old name for the subsequent geological period, which has since been split in two). More correctly it is now referred to as the Cretaceous-Palaeogene, or K-Pg, mass extinction. Continue reading...
|
 |
by Chris McGreal in Fort Lauderdale on (#1EYMT)
Critics say Florida’s efforts to contain an epidemic unleashed within its borders have only had limited effect in curbing one crisis while making another worseFor James Fata, the transition from prescription painkillers to heroin was seamless.The 24-year-old came to Florida to shake an addiction to opioid pills, but trying to go through rehab in a region known as the prescription capital of America proved too much. When a government crackdown curtailed his supply of pills, Fata turned to readily available heroin to fill the void. Continue reading...
|
 |
by Alastair Campbell on (#1EXY0)
The ‘Special One’ arrives at Old Trafford with a big ego but a damaged reputation. What happens next will come down to his ability to learn and adaptNow that he has the Manchester United job he long-coveted, what does the resurrection of José Mourinho, and the demise of Louis van Gaal, say not just about football management but about leadership more generally?The first thing is that if you are looking for lasting friendship and loyalty, you might be better off even in politics than in top-flight football management. There has been a real lack of class about the way Van Gaal’s departure has been handled, his one moment of triumph in winning the FA Cup last Saturday totally wrecked by the breaking news that he would soon be on his way. Continue reading...
|
 |
by Phil Daoust on (#1EY2A)
Every day millions of internet users ask Google life’s most difficult questions, big and small. Our writers answer some of the commonest queriesAre you going to die? You shouldn’t have to ask, but yes, of course you are. Of the 107 billion or so humans who have walked the Earth, 100 billion have already gone to meet their maker. Not one has survived longer than 122 years and 164 days. And if what you really want to know is “Am I about to die?†because you’ve accidentally drunk weedkiller or your chest hurts and you’re short of breath, stop Googling, you numpty. Call an ambulance.In the UK, the Office for National Statistics puts life expectancy at 79.1 years for a baby boy, and 82.8 years for a baby girl. What’s likely to kill you? Illness, rather than accident or violence. If you’re male, the number one cause of death is heart disease, followed by lung cancer and dementia or Alzheimer’s; if you’re female, dementia or Alzheimer’s, followed by heart disease and cerebrovascular diseases. Continue reading...
|
 |
by Press Association on (#1EY16)
NHS Improvement says prescriptions by GPs for all types of antibiotic down by more than 2.6m compared with last year
|
 |
by Steven Shapin on (#1EY17)
From Nazi eugenics to biotech and the desire to make better versions of ourselves … this vivid survey is controversial, but gives the latest on the nature-nurture debateSiddhartha Mukherjee calls his history of genetics “intimate†for two reasons. First, he repeats the cinematic cross-cutting of the personal and the scientific that structured his magnificent history of cancer, The Emperor of All Maladies (2011). The earlier book includes stories about his own patients (Mukherjee was then an oncologist at Massachusetts general hospital, now he is a staff physician at Columbia University Medical Center in New York). Modern cancer medicine is science, but its therapies are delivered at the bedside to patients, sometimes for many years. Cancer is increasingly a modern way of life, not just a way of death, and being a “cancer victim†and a “cancer survivor†both contribute to sufferers’ sense of who they are.But not even cancer defines personal identity as powerfully as your genes are now thought to do. In the new book, some of the cross-cut intimacies emerge from Mukherjee’s own Bengali family – a father with a genetically based brain pathology; a mother whose identical twin displayed both the expected similarities with her sister and some surprising differences; and, especially, the sudden appearance of schizophrenia in apparently healthy cousins and uncles, erupting from genetic legacies lying latent within. Shared genetic inheritances were understood to define the family members’ past, their present and their fears about personal futures. Early on in his relationship with his wife-to-be, Mukherjee was compelled to tell her about madness in the family: “It was only fair to a future partner that I should come with a letter of warning.†Continue reading...
|
 |
by Press Association on (#1EWZS)
Exposure to vehicular and industrial emissions heightens risk during pregnancy, researchers sayExposure to air pollution may increase the risk of stillbirth, new research suggests.Stillbirths, classed as such if a baby is born dead after 24 weeks of pregnancy, occur in one in every 200 births. Around 11 babies are stillborn every day in the UK, with aproximately 3,600 cases a year. Continue reading...
|
 |
by Tim Dowling on (#1EW18)
The Republican candidate has been dismissive of global warming. But when it comes to his golf course in Ireland, he seems to be taking the threat seriouslyA golf-and-hotel complex on the west coast of Ireland has applied to construct extensive dune erosion defences to mitigate the effects of erosion “due to sea level rise and increased Atlantic storminessâ€. An investigation by the US news website Politico found that the environmental impact statement included with the application specifically uses climate change to justify the defence scheme. “If the predictions of an increase in sea level rise as a result of global warming prove correct … it is likely that there will be a corresponding increase in coastal erosion rates,†it says.Why is this interesting? Because the resort in question is the Trump International Golf Links and Hotel. The golf course, for as long as it remains above water, is owned by a US presidential candidate, who has dismissed global warming as a “total hoaxâ€. He’s also called it “bullshit†and a con, and although he now claims it was a joke he once tweeted that global warming was invented by the Chinese to make US manufacturing less competitive. Continue reading...
|
 |
by Lindsey Fitzharris on (#1EVG0)
Holy items – such as the fragment of Becket’s bone returned to England – attract thousands. But ‘secular relics’ carry as much weight for the devotees of science and the artsThis week, a fragment of bone believed to come from the body of Thomas Becket returns to England for the first time in more than 800 years. The relic, which survived the Reformation, will go on a tour through London and Kent before returning to the Basilica of Esztergom in Hungary, where it has resided since the Middle Ages.There are many secular relics around the world that carry as much, if not more significance for their devotees Continue reading...
|
 |
by Tom Dart on (#1EV8W)
Facilities across the US are offering angry people the chance to smash things to their heart’s delight – but experts warn that any satisfaction is only temporaryShawn Baker had an entrepreneurial epiphany years ago when she saw a group of young people outside a concert venue throwing junk out of a truck and pulverizing the trash with a bat. It looked fun. She wondered: could there be a way of monetizing our appetite for mindless destruction?Baker, though, had a good, steady career as manager of a hydraulic shop for a large oil company in Houston. So she put the idea on hold. Continue reading...
|
 |
by Dean Burnett on (#1ETW9)
The debate over whether fat is actually bad for our health overlooks a more fundamental issue: if we know something is bad for us, why can’t we stop eating it? The weird relationship between our brains and digestive systems holds the answer
|
 |
by Zoe Williams on (#1ESRW)
We need to rethink our view of jobs and leisure – and quickly, if we are to avoid becoming obsoleteRobin Hanson thinks the robot takeover, when it comes, will be in the form of emulations. In his new book, The Age of Em, the economist explains: you take the best and brightest 200 human beings on the planet, you scan their brains and you get robots that to all intents and purposes are indivisible from the humans on which they are based, except a thousand times faster and better.Related: The Guardian view on artificial intelligence: look out, it’s ahead of you | Editorial Continue reading...
|
 |
by Ian Sample Science editor on (#1ES0D)
Sir Venki Ramakrishnan says risks and benefits of germline therapy, which is banned in Britain, should be debatedThe genetic engineering of humans has great potential to help those destined to inherit serious, incurable diseases, according to one of Britain’s most prominent scientists, who says the risks and benefits should be debated by society.The invention of powerful new genome editing tools means researchers can now make precise changes to genetic material, and so consider correcting faulty DNA in human sperm, eggs and embryos. Continue reading...
|
 |
by Nicola Davis on (#1ER8J)
Chinese find suggests barley was used for booze before being grown for food - and that beer could have played a role in the development of societyChinese villagers could have been raising a pint 5,000 years ago, according to new research.Archaeologists studying vessels unearthed in the Shaanxi province of China say they’ve uncovered beer-making equipment dating from between 3400 and 2900 BC - an era known as the late Yangshao period - and figured out the recipe to boot.
|
 |
by Maev Kennedy on (#1EQVD)
Thousands of volunteers have helped to uncover the full and devastating extent of the population collapse caused by the epidemicScraps of broken pottery from test pits dug by thousands of members of the public have revealed the devastating impact of the Black Death in England, not just in the years 1346 to 1351 when the epidemic ripped Europe apart, but for decades or even centuries afterwards.The quantity of sherds of everyday domestic pottery - the most common of archaeological finds - is a good indicator of the human population because of its widespread daily use, and the ease with which it can be broken and thrown away. By digging standard-sized test pits, then counting and comparing the broken pottery by number and weight from different date levels, a pattern emerges of humans living on a particular site. Continue reading...
|
 |
by Alex Bellos on (#1EQN8)
Answers to today’s network puzzleEarlier today I set you the following dot-to-dot puzzles. You had to draw lines between the dots, with the constraint that the number by the dot determines the number of lines joining that dot. Continue reading...
|
 |
by Nicola Davis on (#1EQCB)
The UK’s influence over regulation could be reduced and waiting times for new drugs and medical devices to become available increased, warn scientistsLeaving the EU could mean it takes several months longer for new drugs and medical devices to become available in the UK, and reduce Britain’s influence in how such products are regulated, experts have warned.At present, the European Medicines Agency (EMA), which approves new medicines and medical devices across Europe is based in London. Continue reading...
|
|
by Filippa Lentzos and Nicholas Evans on (#1EQ7D)
Trust in biologists is in a precarious position. Secrecy, safety breaches and controversial experiments are risking the reputation of biomedical science. Ahead of a key meeting in the USA, Filippa Lentzos and Nicholas Evans outline steps to earn back the trust of citizens.18-months of deliberation on how to regulate research enhancing the transmissibility and virulence of viruses will end when the National Science Advisory Board for Biosecurity (NSABB) meets on 24 May 2016. The modified pathogens created through so-called ‘gain-of-function’ experiments could, if accidentally released from labs or deliberately misused, cause man-made pandemics. A new regulatory framework for gain-of-function research could set a significant precedent by creating a new standard for oversight in the life sciences.Scientists and innovators assure us that biological technologies will ultimately be beneficial, but trust in biologists is currently in a precarious state. Last week it was revealed that a handful of labs operated by the Centers for Disease Control and Prevention (CDC) faced serious and repeated sanctions, and even secretly had their permits suspended for serious safety violations while working with bioterror pathogens. The CDC’s lab operations have been under scrutiny since 2014, after a series of safety incidents at the agency’s headquarters in Atlanta involving Ebola, anthrax and a deadly strain of bird flu. At the National Institutes of Health (NIH), 30-year old live smallpox virus was found in a disused refrigerator, when it was meant to be safely locked away in only two laboratories in the world. Then the US military mistakenly sent shipments of live anthrax from its highly restricted 800,000-acre site in the Utah desert to nearly 200 labs around the world, including labs in the UK. Continue reading...
|
 |
by Raksha Dave on (#1EQ2F)
Archaeology classrooms are becoming more representative, but we need practitioners with more varied backgrounds and perspectivesAs a British Asian woman, I am one of a small handful of black, Asian and minority ethnic (BAME) people to carve out a lengthy career in the archaeology sector. This is a problem.In 2013, the Chartered Institute for Archaeologists (CIfA) published its Profiling the Profession (pdf) report, which included a section on ethnicity. We are 99% white, with a miserly 1% “other†ethnicities. There are about 6,000 people employed in the archaeology sector in the UK. Of the 837 respondents, seven described themselves as non-white – and one of those was me. Continue reading...
|
 |
by Mona Chalabi on (#1EPP2)
As a second generation immigrant, the way I pronounce my name is different to how my parents say it. But it’s my choice, and I refuse to feel guilty about itLike most people, I did not get to choose my name. It was my parents who decided that ‘Mona’ was a befitting title for their generic but sentimentally special latest offspring. I didn’t get a say about the noun that I will carry around for the rest of my life. But I do get to choose the pronunciation.I could pronounce my name ‘MO-nah’ to rhyme with such classy words as ‘boner’ and ‘loner’. Or I could pronounce it ‘Mu-na’, which said aloud, rhymes with nothing that I can think of in the English language. That’s because ‘Mu-na’ is the way that Arabic speakers (like my parents) would say my name. Now we get to the tricky waters which I, along with many second generation immigrants, must navigate – which phonetic version of my name should I present to the world? Continue reading...
|
 |
by Gustav Milne on (#1EPN0)
However ‘civilised’ we may now consider ourselves to be, biologically we remain much as we were before we began farming and moved into cities. Can we create a healthier future by returning to our paleolithic past?The city is not our natural habitat. For the last three million years, we evolved as hunter-gatherers, living in small tribal societies, breathing fresh air, drinking fresh water and eating fresh foods. But more than half of us now live in cities. Culturally, our society is transforming, but anatomically, our genetic evolution is slower: we remain much as we were even before large-scale farming was adopted 5,000–10,000 years ago.However “civilised†we may now consider ourselves to be, biologically we are much closer to our stone age ancestors. There is a major mismatch between our modern urbanised world and our “paleolithic genomeâ€, the genetic material encoded in our DNA, which supports an ancient hunter-gatherer lifestyle.
|
 |
by Stephen Curry on (#1EPKQ)
Being wrong is easier than you think. So how can you be sure you will make the right choice in the EU referendum?I have to start with a confession: I don’t think I’m wrong about Britain’s membership of the EU. I’ve weighed up the pros and cons and in the referendum on 23 June I will in all likelihood be voting to remain. And nor do I think that you will feel you have erred in determining your position on the Brexit debate, whatever that may be.But both of us are wronger than we think – probably – and not just because it is so difficult to establish the facts amid the noise of the ill-tempered, ill-informed and often mendacious debate on the rights and wrongs of the EU – to say nothing of the intrinsic biases of news reporting. There’s also the deeper matter of our built-in and rather slippery aptitude for error, a topic explored in all its intriguing dimensions in Kathryn Schulz’s Being Wrong, which I turned to last week in the midst of my struggles with the EU referendum. Continue reading...
|
 |
by Gene Blevins / Zuma / Rex on (#1EPFH)
Photographs from the Eyewitness series Continue reading...
|
 |
by Nicola Davis on (#1EPC9)
Fossilised skeleton of a toothless animal that lived 247 million years ago opens a window to a time of remarkable diversity on Earth after the ‘Great Dying’ eventThe discovery of a toothless animal with a short snout and a long tail that roamed the seas around 247 million years ago, suggests early marine reptiles evolved more rapidly than previously thought after the the most devastating mass extinction event the planet has ever experienced, scientists have revealed.Dubbed Sclerocormus parviceps, a name that nods to its rigid body and small skull, the ichthyosauriform was unearthed by fossil hunters in China. Continue reading...
|
 |
by Amy Fleming, Richard Vine, Michael Tait, Troy Grig on (#1EPKS)
Colour, sound and shape are just as important as sugar and salt in determining how food tastes. Why do senses combine in our brains - and will a red light bulb really make cake sweeter? Tamal Ray takes us on a scientific tour of gastrophysics Continue reading...
|
 |
by Linda Geddes on (#1EP4X)
Despite 100 years of medical advancement, old-fashioned infections are creeping back into Britain. Should we be worried?The notice pinned to the door of my son’s nursery in Bristol made me start: “A child at this nursery has been diagnosed with scarlet fever.†Googling the symptoms, I found images of peeling, strawberry-red tongues and blotchy rashes, but it was the name that really gave me the shivers. Charles Darwin lost two of his children to scarlet fever; it just seemed so, well, Victorian.A few days later, the nursery informed us of a second case. However, this localised outbreak is far from unique: as of 8 April, a total of 10,570 cases of scarlet fever had been reported to Public Health England since the season began in September 2015, up from 9,379 during the same period in 2014-15. Continue reading...
|
 |
by Luisa Dillner on (#1EP1B)
While it hasn’t been proved that physical activity mitigates your likelihood of getting the disease, the evidence shows a strong link – so get movingJust in case you haven’t got the message that exercise is good for you, two huge research studies this week shout it louder than ever. Which is just as well, since almost one-third of adults are classified as “inactiveâ€. Exercise is already known to reduce the risk of breast, colon and endometrial cancer (cancer of the lining of the uterus) by between 10% and 40%. Now, a pooled analysis of data from studies looking at 1.4 million adults between the ages of 19 and 98 has found that exercise reduces the risk of an additional 10 cancers, including oesophageal, stomach, bladder and kidney. What’s more, for many cancers, exercise reduces the risk even in overweight people. This is particularly interesting, because the mechanism by which exercise is thought to protect from cancer is weight reduction.It seems that exercise may work its magic in a variety of ways. Dr Marilie Gammon, an epidemiologist from the Gillings School of Global Public Health in Chapel Hill, North Carolina, who wrote an editorial to accompany the paper in the peer-reviewed journal JAMA Internal Medicine, says that exercise may help to repair DNA when it is damaged by cancer-promoting substances. Exercise may also alter hormone levels and reduce inflammation. Continue reading...
|
 |
by Alex Bellos on (#1EP04)
Come on join the networkHello guzzlers,Today we’re drawing lines between dots. Continue reading...
|
 |
by Kate Ravilious on (#1EN03)
Farmers can keep those raindrops falling by turning their sprinklers on
|
|
by Editorial on (#1EMRM)
Preserving the drugs that have extended life expectancy by 20 years by only using them to save lives is a matter of urgency. The drug companies can’t do it. A prize just mightThe Longitude Prize is a very smart idea. The prize is a handsome £8m and it awaits the first individual or (more probably) team that develops a quick, cheap and reliable way of stopping overuse or misuse of antibiotics. The diagnostic – it might be a strip of sensitised paper or it might be a mobile phone app – must be capable of being used anywhere in the world. Next week another round of assessment of ideas begins from the 138 teams so far registered.A prize is smart economics to encourage smart science. It counters the lack of a strong market incentive to develop a diagnostic for which there is an overwhelming need – while reminding the rest of us to remember, next time we see the doctor, the urgency of the crisis. Antibiotics, it is reckoned, add 20 years to life expectancy; resistance is growing so fast that already 700,000 people die each year from untreatable infections. From the exotic, like typhoid, to the all too domestic Clostridium difficile, the pathogens that once succumbed swiftly to penicillin and other antibiotics now fight back. They are becoming killers again. Continue reading...
|
 |
by Andrew Anthony on (#1EKFT)
It’s a mind-bending concept with the potential to change the world, and Canadian tech company D-Wave claims to have cracked the codeEver since Charles Babbage’s conceptual, unrealised Analytical Engine in the 1830s, computer science has been trying very hard to race ahead of its time. Particularly over the last 75 years, there have been many astounding developments – the first electronic programmable computer, the first integrated circuit computer, the first microprocessor. But the next anticipated step may be the most revolutionary of all.Quantum computing is the technology that many scientists, entrepreneurs and big businesses expect to provide a, well, quantum leap into the future. If you’ve never heard of it there’s a helpful video doing the social media rounds that’s got a couple of million hits on YouTube. It features the Canadian prime minister, Justin Trudeau, detailing exactly what quantum computing means. Continue reading...
|
 |
by Ben Ambridge on (#1EPGK)
What do crowds, a social life and intelligence have in common? Take this test and find outMost IQ tests involve answering a whole load of difficult questions. But here’s one with just two. Best of all, they’re simple:1. Does living in a crowded area get you down?
|
 |
by Daniel Keltner on (#1EK3J)
Being grateful is one of the best ways to hold on to power that otherwise might slip awayFor the past 20 years I’ve put two ideas about power to the scientific test. The first is Machiavelli’s: “It is better to be feared than loved.†This thesis has not fared well in studies looking at who rises to power in organisations, schools, communities and military units. It isn’t the coercive, manipulative Machiavellian who rises to power. Instead it is the empathetic, generous person who reaches out to others who gains esteem and rises up the ranks.Lord Acton’s observation that “power tends to corrupt, and absolute power corrupts absolutely,†however, is confirmed time and time again. As we enjoy elevated power, we are more likely to eat impulsively, have sexual affairs, violate the rules of the road, lie, cheat, shoplift, take sweets from children and communicate in disrespectful ways. Continue reading...
|
 |
by Robin McKie Observer science editor on (#1EHAH)
Francis Aston, Edwardian scientific genius, surfer and motorcycling pioneer, was awarded the Nobel in 1922 for his discovery of isotopes. Now his medal is up for auctionThe Nobel prize awarded to one of the world’s most colourful scientists – Francis Aston, an Edwardian surfing fanatic and early pioneer of motorcycle racing – is to be auctioned in London next month.The medal, a 200g disc made of 23-carat gold, was given to Aston in 1922 in recognition of the British chemist’s discovery of isotopes, elements with the same chemical properties but different atomic masses. His Nobel prize for chemistry is being sold by his family and is expected to fetch between £200,000 and £400,000, Bonhams said. Continue reading...
|
 |
by Ashifa Kassam in Toronto on (#1EGV6)
New research takes aim at the fanged portrayal of the T rex, suggesting enamel on its teeth was probably kept moist by thin, scaly lips much like those of lizardsIts image is one of a fierce predator who towered over most others, baring dozens of jagged, bone-crushing teeth.But new research out of Toronto seeks to challenge depictions of the Tyrannosaurus rex, suggesting that its fearsome incisors might have been hidden behind a pair of lips. Continue reading...
|
 |
by Simon Usborne on (#1EGKJ)
The seaside town is the frontrunner in an unlikely UK space race. Could a spaceport launch a new era of prosperity, or is it a galactic dream too far?There is only one gate at Newquay Airport’s departure lounge, where the planes park as close as cars to a petrol station, and the wireless broadband doesn’t work. At the coffee shop’s “Destination Cornwall†display, you can buy clotted cream shortbread, clotted cream fudge and, if your lily required further gilding, Poldark-themed Cornish ale.There’s a newspaper rack, too, which has run out of this week’s edition of the Cornish Guardian. It was published on Wednesday and, next to a voucher for a two-for-one “coffee and traybake†offer at Warrens Bakery, carried a startling front-page story. Continue reading...
|
 |
by Darian Leader on (#1EGKM)
Doctors predict that our increasing use of computers and mobile phones will permanently alter our hands. What will this mean for the way we touch, feel and communicate?The new era of the internet, the smartphone and the PC has had radical effects on who we are and how we relate to each other. The old boundaries of space and time seem collapsed thanks to the digital technology that structures everyday life. We can communicate instantly across both vast and minute distances, Skyping a relative on another continent or texting a classmate sitting at the next table. Videos and photos course through the web at the touch of a screen, and social media broadcast the minutiae of both public and private lives. On the train, the bus, in the cafe and the car, this is what people are doing, tapping and talking, browsing and clicking, scrolling and swiping.Philosophers, social theorists, psychologists and anthropologists have all spoken of the new reality that we inhabit as a result of these changes. Relationships are arguably more shallow or more profound, more durable or more transitory, more fragile or more grounded. Continue reading...
|